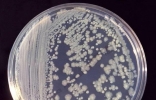

恒河水中1ml就有上10万的细菌 为啥印度人还要喝?(印度恒河水)
印度人已经适应了恒河水里面的污染。干净又卫生这句话是某个网络红人形容印度美食的。很显然就是一句反讽,因为印度人在自制作食物的时候,大多数都是比较埋汰。尤其是他们用的水,基本上都是来自于他们的母亲和恒河 ...
2023-1-14 14:13

一块儿海绵里面拥有超过300种细菌。现在基本上每个家庭都是会做饭的,而大家在洗锅还有洗碗的时候都会用到一种工具,就是洗碗海绵,毕竟这种海绵有着非常好的情节能力,而且价格很低。但是在前段时间有美国的一个研 ...
2023-1-3 13:16

《PLOS ONE》:研究表明国际空间站里充满各种各样的细菌
《PLOS ONE》:研究表明国际空间站里充满各种各样的细菌据cnBeta:外媒报道,当生活在一个偏远、孤立的环境中像细菌和病毒这样的东西可以在很短的时间内造成严重破坏。国际空间站(ISS)绝对算得上是遥远和孤立的,所 ...
2022-1-4 11:34

用力握拳是捏不死手上的细菌的。细菌需要高温将其烤死,而非靠压力,细菌可是能承受100个大气压的!所以,省省力气吧!手掌“用力一捏”是一个宏观物理描述,微观含义是人的肌肉细胞拉着骨骼及大量其他细胞所进行的 ...
2021-12-22 08:25

七步洗手法是医务人员进行操作前的洗手方法,用七步洗手法清洁自己的手,清除手部污物和细菌,预防接触感染,减少传染病的传播。洗手全过程要认真揉搓双手每步15秒以上,特别要注意彻底清洗戴戒指、手表和其他装饰品 ...
2021-12-9 21:32

现在各种各样的疾病是越来越多,任何疾病都是可怕的,早期诊断和必要的治疗可以帮助减轻痛苦。随着科学的发展,一些医疗技术也越来越完善,很多疾病都能够被治愈。但世界上仍有许多痛苦的疾病导致了大量人们死亡或者 ...
2021-12-9 13:27

在自然界中,有很多的微生物,细菌是其中之一。细菌散布在我们生活的方方面面中,所有的生活环境中都有着细菌。细菌对于人类的作用是巨大的,很多重要的作用都有着细菌的身影。任何事物都是具有两面性的,细菌也是如 ...
2021-12-9 13:07

俄罗斯科学家将检查10年来一直搭在国际空间站外边的毛巾上是否有细菌 ...
俄罗斯科学家将检查10年来一直搭在国际空间站外边的毛巾上是否有细菌俄罗斯卫星通讯社莫斯科5月30日电,俄罗斯科学院生物医学问题研究所主任研究员斯韦特兰娜·波杜布柯对卫星通讯社表示,科学家将检查10年来一直搭 ...
2021-7-24 10:51
国际空间站发现肠杆菌菌株 研究它们避免对宇航员造成健康影响 ...
国际空间站发现肠杆菌菌株研究它们避免对宇航员造成健康影响据EurekAlert!:最近发表在开放获取期刊《BMC微生物学》(BMC Microbiology)上的一项研究显示,科学家们已确认在国际空间站内发现了一些肠杆菌(Enteroba ...
2021-7-5 12:56

科学家在国际空间站上发现与地球肠道杆菌相似的细菌。美国太空总署(NASA)的科学家,把在国际空间站(ISS)采集的细菌基因,与在地球上的细菌基因对比,结果发现当中5种与地球上的3种细菌最为相似。科学家指这些在I ...
2021-7-4 17:48

大家一起唱起来:我的热情,好像一把火,燃烧整个沙漠。是不是瞬间点燃你心中那份激情,沙漠在人们脑海中印象是宽广无垠的,环境十分恶劣。不过这还只是一般的沙漠,要说世界上最恐怖沙漠估计你都没有听闻过,下面就 ...
2021-7-4 17:46

培养皿采干手器空气,2天长满原体霉菌,烘手机像细菌喷射机 ...
正修读微生物学课程的美国女大学生沃德(Nichole Ward),在洗手间的干手机作了一项实验,把培养皿放在干手机内3分钟,再等候48小时。结果培养皿长满了形状可怖的真菌,照片在facebook疯传。不过,沃德的实验是否严 ...
2020-5-6 12:12

说到净水器,你可能想到的是家中饮水机上的大家伙,也可能是净水龙头。但是世界最小的净水器只有2cm,喝水的时候一不小心就吞下去了,还记得小时候喝了自来水都会拉肚子,有了这个易携带的世界最小的净水器,妈妈再 ...
2019-7-14 18:46

巨人观就是形容死掉的人的尸体变大变膨胀的现象。巨人观是因为人死了,整个身体的平衡打破了,体内细菌就不断的繁殖生长,把尸体撑大了。这种现象被应用在很多故事里,特别是僵尸故事里面。僵尸的形象就是体型大,力 ...
2019-7-14 04:21

口臭是什么原因对于很多有口臭的人来说都想弄明白。现在科学意见搞明白了口臭是什么原因。口臭主要是三种原因,一种是食物残留造成的臭味,一种是人体内部胃热、上火,还有一种就是口腔炎症造成的。知道了口臭是什么 ...
2019-7-14 04:18

细菌是一种无处不在的微小生物,而且对人们的生活是有一定影响的。细菌可以引发许多的疾病,在人们的印象里,他好像是百害而无一利,但是事实并不是这样的。近几年人们发现细菌在其他方面也有用处,下面就让我们来看 ...
2019-7-13 22:33

现在越来越多的人家中养狗了,也有很多人养的特别奇葩的一种狗,说到哈士奇,大家都知道它的二了,看上去傻傻的,对主人也是非常的听话温和,长相憨态可掬,但是很多人不知道怎么去养它。比如哈士奇和阿拉斯加长得很 ...
2019-7-13 21:47

我们现在的生活水平很高,可以随时随地知道我们想要的东西,但是因为我们这种想法,很多人都不注重自己身体的健康问题,现在有很多人在年轻的时候就患有多种疾病,有些疾病虽然非常小,但是却让我们非常痛苦,那么虫 ...
2019-7-13 19:42

相信大家一定听说过消毒液这种东西,但是应该很少有人知道消毒液究竟有哪些种类,并且每种消毒液都是用来干嘛的。在家庭中,不少妈妈会选择使用衣物消毒液来防止衣物滋生细菌,保卫家人的健康。在公共区域,消毒液也 ...
2019-7-13 16:58

说到净水器,你可能想到的是家中饮水机上的大家伙,也可能是净水龙头。但是世界最小的净水器只有2cm,喝水的时候一不小心就吞下去了,还记得小时候喝了自来水都会拉肚子,有了这个易携带的世界最小的净水器,妈妈再 ...
2019-7-13 16:12